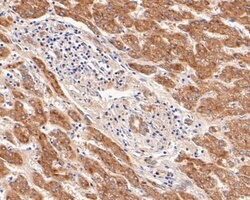
Invitrogen Follicle Stimulating Hormone Polyclonal Antibody 100 &mu;L;

missing translation for 'onlineSavingsMsg'
Learn More
Learn More
Invitrogen™ Follicle Stimulating Hormone Polyclonal Antibody


Rabbit Polyclonal Antibody
Marca: Invitrogen™ PA5111750
Este artículo no se puede devolver.
Vea la política de devoluciones
Descripción
Positive Control: SH-SY5Y cell, rat pituitary tissue, human pituitary tissue, human liver tissue, mouse pituitary tissue, SH-SY5Y.
Follicle-stimulatine hormone (FSH) is a member of the glycoprotein hormone family. Members of this family consist of an identical alpha subunit and a hormone-specific beta subunit. Alternative splicing results in two transcript variants encoding the same protein. FSH is secreted by gonadotropic cells in the pituitary gland and in conjunction with luteinizing hormone, induces egg and sperm production.
Especificaciones
| Follicle Stimulating Hormone | |
| Polyclonal | |
| Unconjugated | |
| FSHB | |
| class 1 follicle-stimulating hormone beta polypeptide; class 2 follicle-stimulating hormone beta polypeptide; follicle - stimulating hormone subunit beta; follicle stimulating hormone beta; follicle stimulating hormone beta subunit; follicle stimulating hormone beta-subunit precursor; follicle stimulating hormone subunit beta; follicle stimulating hormone, beta polypeptide; follicle-stimulating hormone beta subunit; follicle-stimulating hormone beta-subunit; follicle-stimulating hormone subunit beta; follicule stimulating hormone, beta polypeptide; follitropin beta chain; Follitropin subunit beta; follitropin, beta chain; FSH; FSH-alpha; FSHB; FSH-B; Fshbeta; FSH-beta; HH24; LSH-alpha; prefollicle stimulating hormone beta chain; TSH-alpha | |
| Rabbit | |
| Antigen affinity chromatography | |
| RUO | |
| 2488 | |
| -20°C, Avoid Freeze/Thaw Cycles, store in dark | |
| Liquid |
| Flow Cytometry, Immunohistochemistry (Paraffin), Western Blot | |
| 1 mg/mL | |
| PBS with 0.2% BSA, 50% glycerol and 0.05% sodium azide; pH 7.4 | |
| P01225 | |
| FSHB | |
| Synthetic peptide within Human FSH beta aa 37-86. | |
| 100 μL | |
| Primary | |
| Human | |
| Antibody | |
| IgG |
Corrección del contenido de un producto
Proporcione sus comentarios sobre el contenido del producto rellenando el siguiente formulario.
Título del producto
¿Detecta una oportunidad de mejora?Comparta una corrección de contenido